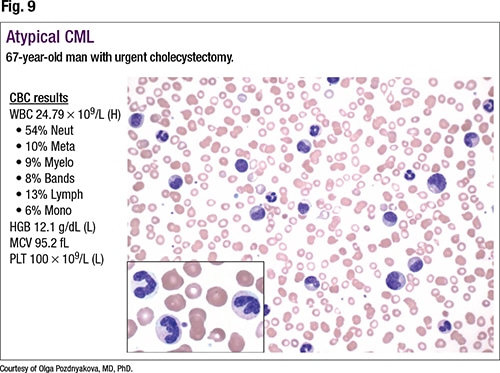

She and colleagues use NGS to assess for disease progression. “Either we’ll look for an increased allele burden, or for the presence of mutations that we know are associated with a worse prognosis.” They also use NGS to monitor treatment—emergence of the ABL1 resistance mutations, for example, or for targetable mutations, such as FLT3 or IDH1/2.
Before reporting the patient’s remaining test results, Dr. Pozdnyakova reviewed two more diagnoses that present with peripheral blood neutrophilia that she said are in the differential diagnosis for other patients. The first is chronic neutrophilic leukemia, defined as a persistent neutrophilia in peripheral blood and bone marrow with organomegaly and absence of BCR-ABL1 translocation. Among the clinical features is neutrophilia greater than 25,000 without left shift. “Neutrophils could have hypergranular cytoplasm. Sometimes those cases could be accompanied by increased platelets. Hemoglobin levels could be normal. We tend to associate those cases with CSF3R mutations,” she said. “However, other mutations, such as ASXL1, SETBP1, or JAK2, have been described. There is no specific therapy, but some patients respond to JAK inhibitors and tyrosine kinase inhibitors.” CNL closely resembles CML with p230 or atypical CML. “And we always need to exclude non-neoplastic neutrophilia because sometimes the morphologic findings could be very subtle.”
The second diagnosis in the differential is atypical CML (Fig. 9). “Similar to typical CML, patients present with left-shifted granulocytosis,” she said, pointing to metamyelocytes, myelocytes, and bands on the smear. “However, when you look closely at the morphology of those cells, there is significant dysplasia,” she added, noting hypergranular cytoplasm and abnormal nuclear lobation. “Also, since there is an MDS component to that neoplasm, these patients tend to present with anemia and lower platelet counts.”
The second diagnosis in the differential is atypical CML (Fig. 9). “Similar to typical CML, patients present with left-shifted granulocytosis,” she said, pointing to metamyelocytes, myelocytes, and bands on the smear. “However, when you look closely at the morphology of those cells, there is significant dysplasia,” she added, noting hypergranular cytoplasm and abnormal nuclear lobation. “Also, since there is an MDS component to that neoplasm, these patients tend to present with anemia and lower platelet counts.”
Atypical CML is an MDS/MPN overlap syndrome with persistent leukocytosis with left shift, prominent dysplasia, organomegaly, and absence of BCR-ABL1 translocation, Dr. Pozdnyakova said. “This is an extremely rare diagnosis, presenting almost exclusively in an older patient population,” with a WBC count of greater than 13,000 with a significant left shift, defined as greater than 10 percent of the WBCs, and significant dysplasia. There is no standard therapy, she said, and patient survival is poor. One-quarter to one-third of cases are associated with the SETBP1 mutation. “However, similar to other MPN/MDS diagnoses,” she said, “you can see nonspecific ASXL1, RAS, SRSF2, TET2, CBL, JAK2, or other mutations. And it closely resembles chronic myeloid leukemia or chronic neutrophilic leukemia, and you have to carefully examine a peripheral blood smear to look for morphologic dysplasia, which will allow you to differentiate this diagnosis from CML and CNL.”

